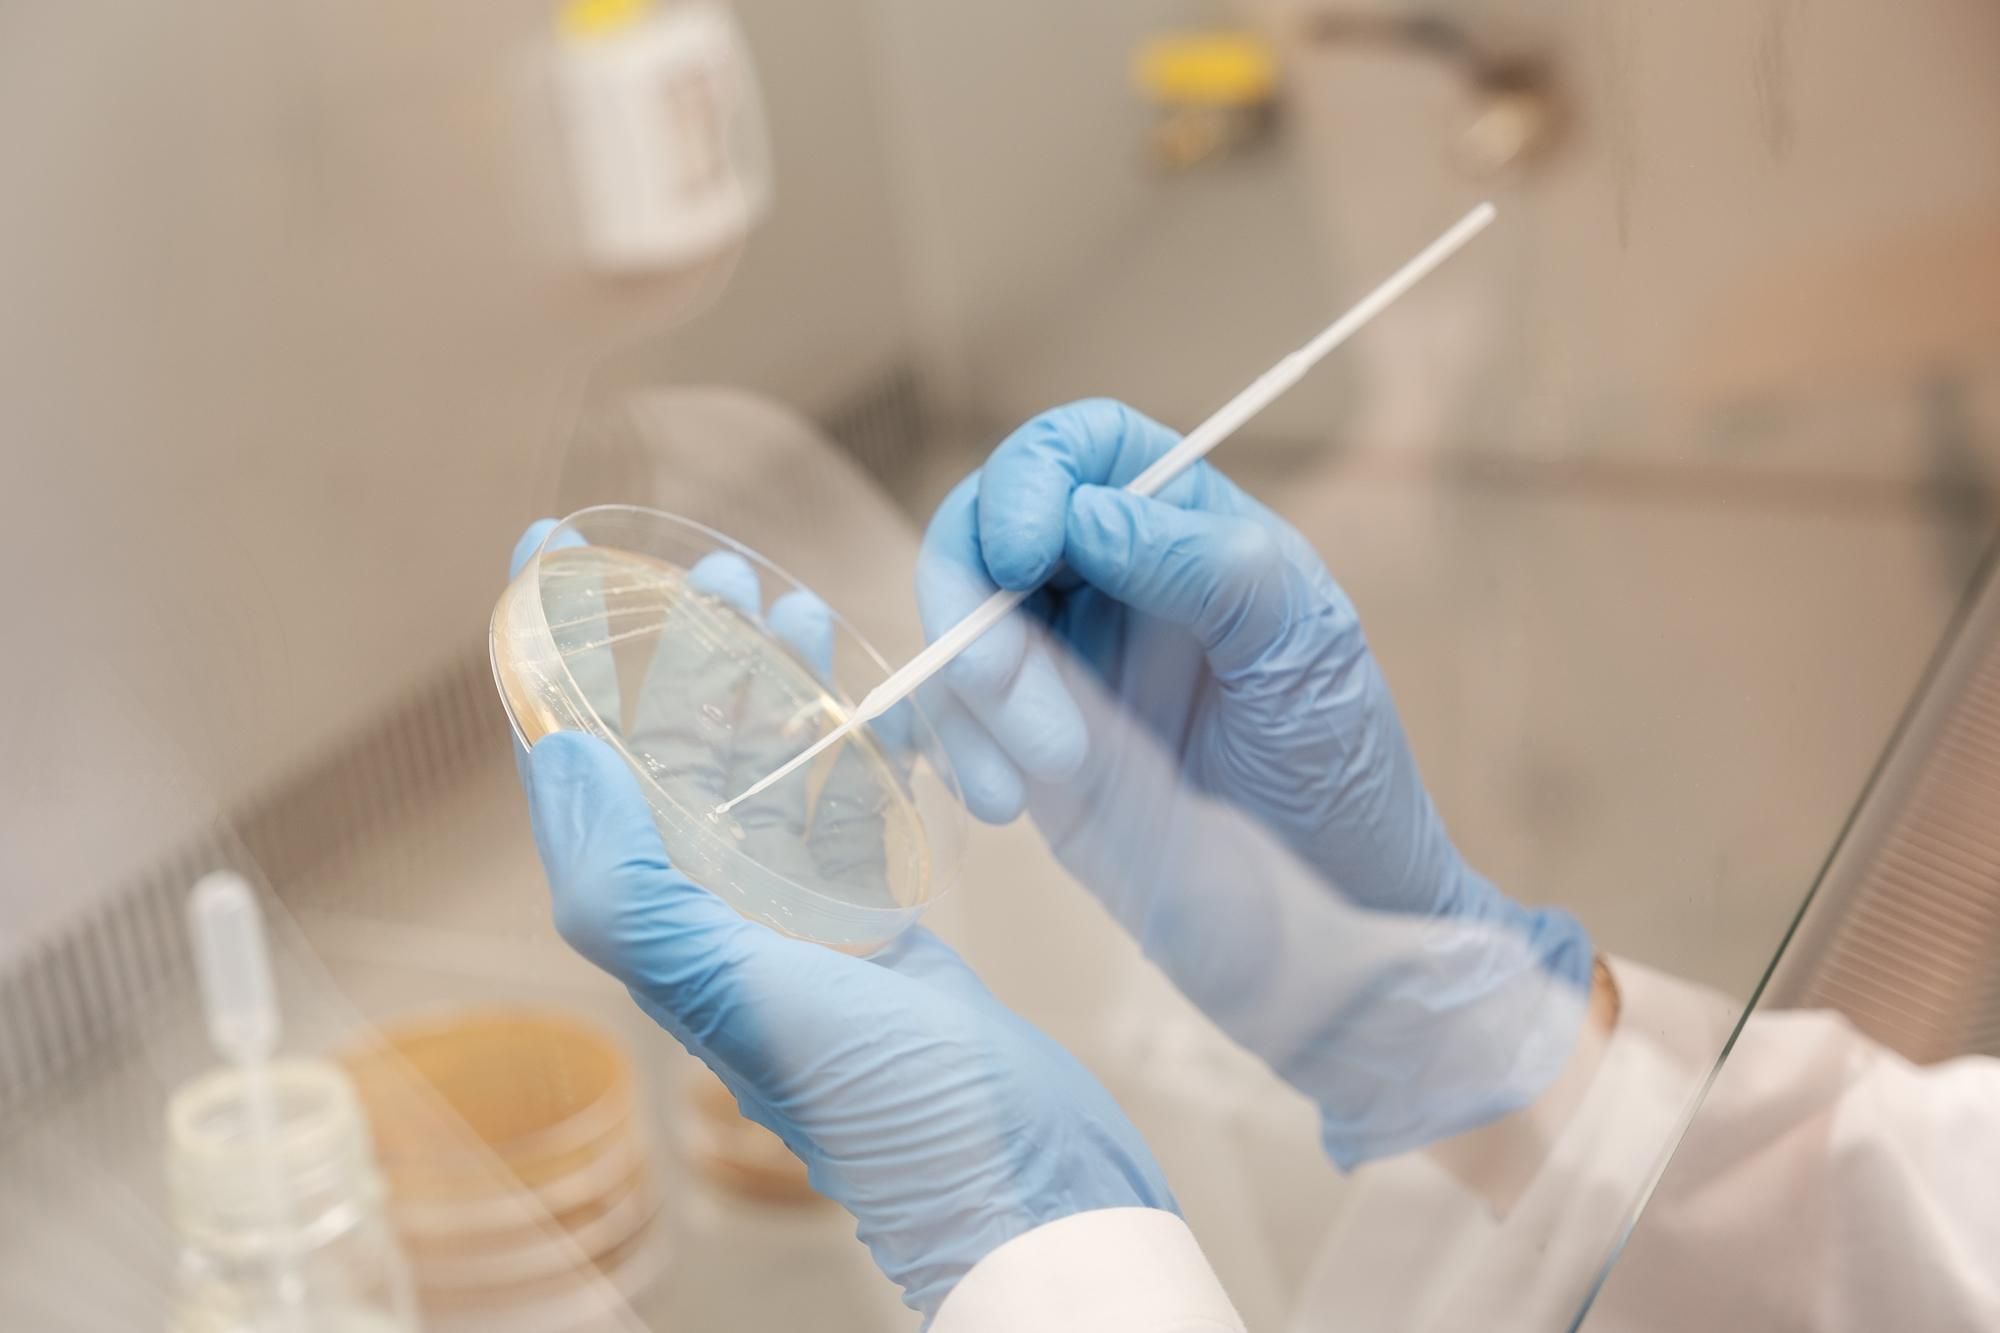

Studio di batteri lattici produttori di folati per la bio-fortificazione di prodotti caseari

La carenza di folati nella dieta è un fattore di rischio, forse il principale, per l’insorgenza di patologie dipendenti da un alterato metabolismo di questo nutriente essenziale: dai difetti congeniti, alle patologie cardiovascolari, tumorali, neurodegenerative. È evidente, pertanto, il ruolo cruciale rappresentato dal livello di assunzione di folati con la dieta e di conseguenza la necessità di mettere in atto interventi di salute pubblica consistenti essenzialmente in strategie mirate ad arricchire il contenuto in folati della dieta. «Il nostro lavoro parte dal creare alimenti che siano alternativi agli integratori» spiega Daniela Bassi, ricercatrice che opera all’interno del Dipartimento di Scienze e tecnologie alimentari per una filiera agro-alimentare sostenibile. «Il primo passo è analizzare i batteri lattici, normalmente utilizzati per la produzione di prodotti caseari, per la loro capacità di produrre acido folico. Questa potenzialità può essere sfruttata per ottenere alimenti, quali yogurt e formaggi, ricchi in folati».